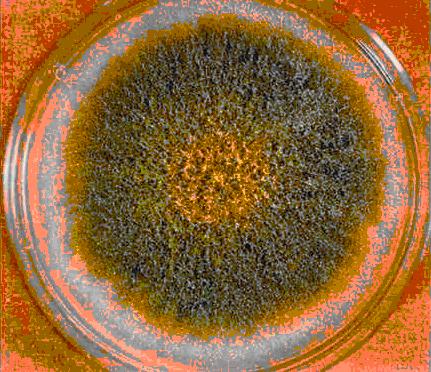

11月1日,云南省市場監督管理局通報,近期該局完成國家市場監督管理總局食品安全監督抽檢任務323批次,涉及糧食加工品、食用油、油脂及其制品、調味品、肉制品、乳制品、方便食品、等6大類產品,發現2批次不合格方便食品樣品。
其中1批次為:騰沖市贏興商貿有限責任公司云騰餌絲廠生產的騰沖餌絲(麻辣排骨味),該樣品檢出菌落總數不符合食品安全國家標準規定。
菌落總數是指示性微生物指標,主要用來評價食品清潔度,反映食品在生產過程中是否符合衛生要求。《餌絲(片)》(Q/YTE 0001 S-2016)中規定,騰沖餌絲(麻辣排骨味)菌落總數,一個樣品的5次檢測結果均不超過105CFU/g,且至少2次檢測結果不超過104CFU/g。造成菌落總數超標的原因,可能是個別企業未按要求嚴格控制生產加工過程的衛生條件,或者包裝容器清洗消毒不到位;還有可能與產品包裝密封不嚴,儲運條件控制不當等有關。
另1批次不合格樣品為:大姚御春農食品有限公司生產的芡實茯苓紅棗粉(方便食品),該樣品檢出霉菌不符合食品安全國家標準規定。
霉菌是真菌的一種,其特點是菌絲體較發達,無較大的子實體。同其他真菌一樣,也有細胞壁,寄生或腐生方式生存。霉菌有的使食品轉變為有毒物質,有的可能在食品中產生毒素,即霉菌毒素。霉菌毒素對人和畜禽主要毒性表現在神經和內分泌紊亂、免疫抑制、致癌致畸、肝腎損傷、繁殖障礙等。《方便沖調食品》(Q/YCN 0006 S-2019)中規定,芡實茯苓紅棗粉(方便食品)中霉菌,一個樣品的5次檢測結果均不超過102CFU/g,且至少2次檢測結果不超過50CFU/g。造成霉菌超標的原因可能是環境潮濕,不通風,半成品被污染,或者是原材料帶入,也可能是半成品殺菌效果差或未達到要求,還有可能是成品密封性差,存儲過程被污染等有關。
對騰沖市贏興商貿有限責任公司云騰餌絲廠、大姚御春農食品有限公司抽檢中發現的不合格產品,云南省市場監督管理局將責成企業所在地監管部門按照《中華人民共和國食品安全法》的規定,責令生產經營企業及時采取下架、召回等措施,進一步調查處理,查明生產不合格產品的批次、數量和成因,制定整改措施。
農藥殘留檢測儀m.sh-xunning.cn




 微信掃一掃
微信掃一掃